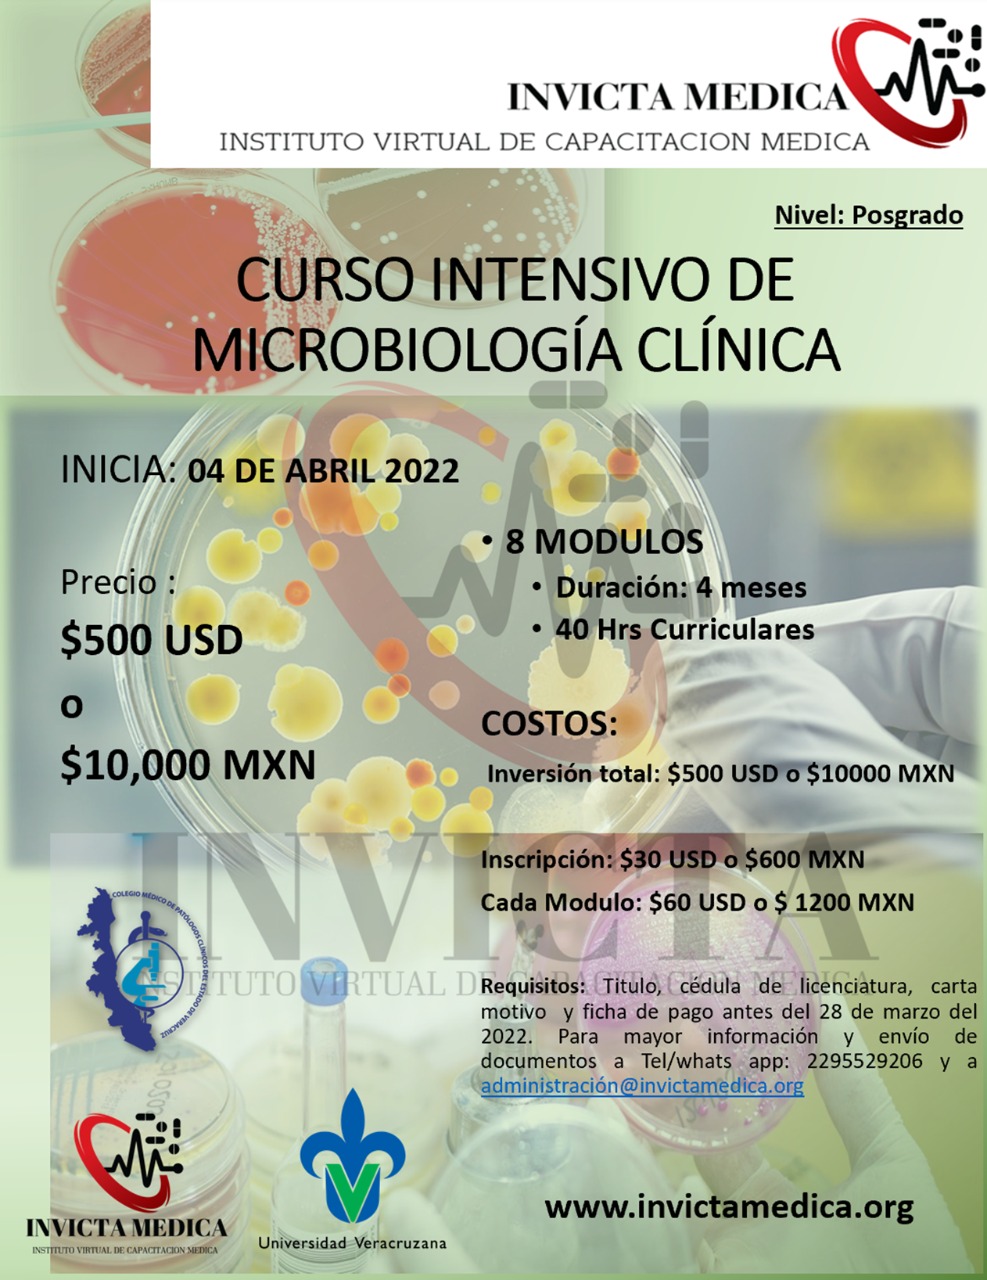

Por primera vez en México, existe un Diplomado de Medicina Transfusional hecho a la medida de las necesidades de los profesionales de Salud, que se adapte a los horarios y ritmos de vida de cada uno.
Hecho por profesionales y expertos en la materia con los temas mas relevantes y actualizados en apego a los artículos más actualizados y tecnología de vanguardia para el desarrollo e investigación de la medicina transfusional a nivel mundial.
Diseñado con finalidad de darle a los profesionales de la salud herramientas para el desarrollo del tema tan basto y completo para que los servicios de transfusión, centros de colecta y bancos de sangre operen administrativa y operacionalmente de la mejor manera.
Avalado por la Universidad Veracruzana, el Colegio Médico de patólogos clínicos del Estado de Veracruz, EL Centro Estatal de La transfusión de Sangre son algunas de las Instituciones de Prestigio que nos respaldan.